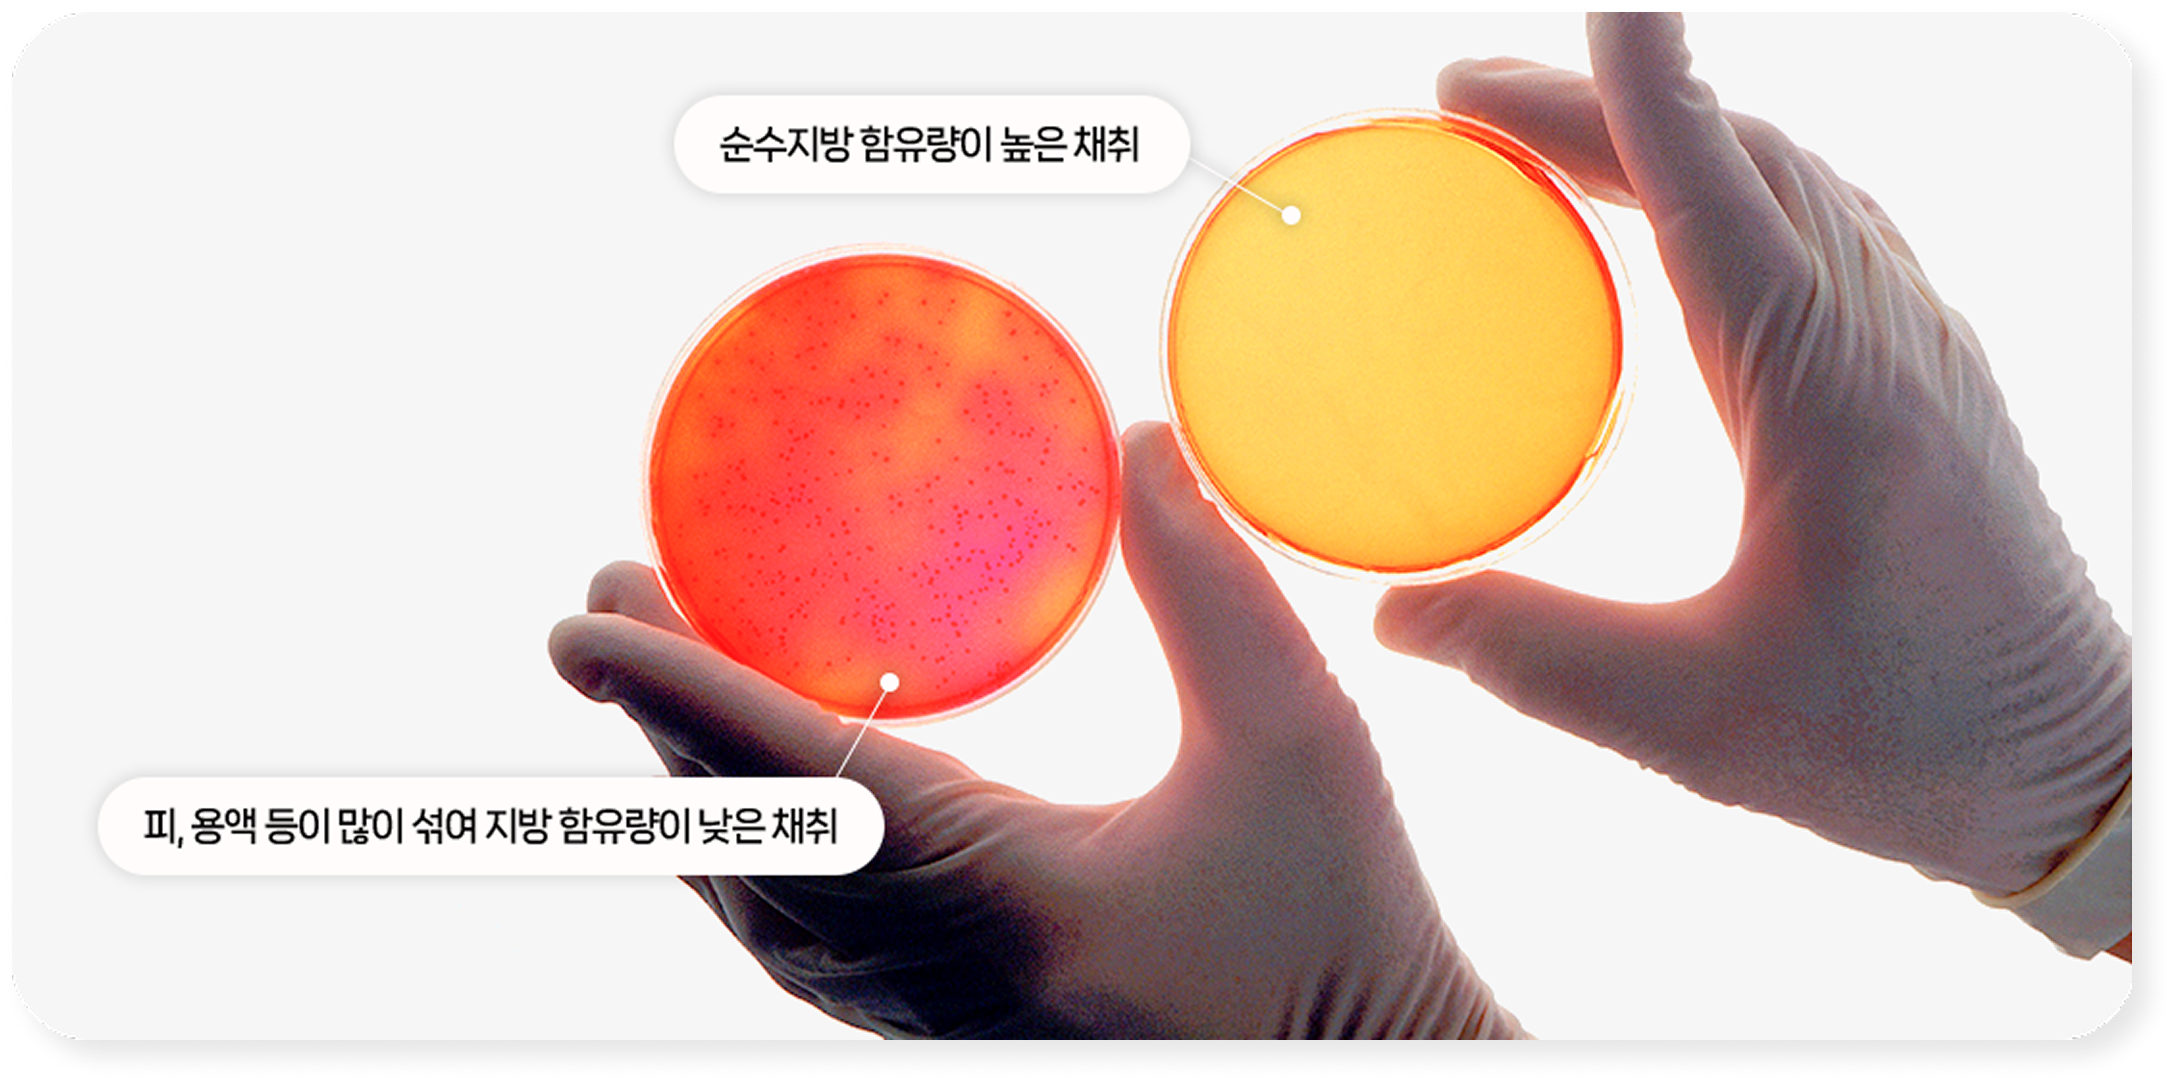
심부볼 지방제거 4

Buccal Fat Removal
심부볼 지방제거
갸름한 동안 페이스의 핵심

입안의 작은 절개로 진행되어 흉터 걱정이 없으며,
사탕을 문 듯 부어 보이던 볼살을 개선하여 나이가
들어 보이는 인상을
갸름하고 세련된 이미지로 바꿔줍니다.

AZ Plastic Surgery
이런 분들에게 추천합니다!
작고 슬림한 V라인 얼굴형을 원하는 경우
과한 얼굴살 때문에 둔해 보이는 경우
몸에 비해 얼굴에 유독 살이 많으신 분
이중턱이 심해 목과 턱의 경계가 뚜렷하지 않은 경우
안면윤곽 수술과 동시에 시행하여 더욱 갸름한 얼굴을 원하는 경우


AZ Plastic Surgery
이중턱/심부볼 제거 수술부위

심부볼 지방제거
(윗볼)
아랫뺨
지방흡입
이중턱 지방흡입
이중턱/심부볼 제거 후 주의사항
처방받은 가글은 하루 3회 이상 꾸준히 사용해주세요.
수술 후 2~3주간은 맵고 짠 자극적인 음식은 피해주세요.
양치 시 볼 안쪽을 과도하게 자극하지 않도록 조심해주세요.
입을 크게 벌리거나 무리한 표정 움직임은 삼가주세요.
고혈압, 당뇨, 심장 질환 등 기저질환이나 복용 중인 약물이 있으신 경우, 반드시 의료진에게 미리 알려주시기 바랍니다.
음주 및 흡연은 출혈 및 회복 지연의 원인이 될 수 있으므로, 수술 후 2~3주 이상 피해주세요.
![<span class='text-[#3F556E] text-[40px] font-bold'>심부볼 지방제거</span>](/images/fat/fatbg.png)